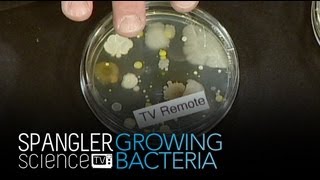
Growing Bacteria - Cool Science Experiment

Grow a bacteria culture
Grow a harmless bacteria culture by making yogurt using store-bought yogurt as a starter and warm milk, then observe and record growth safely.



Step-by-step guide to grow a harmless bacteria culture by making yogurt
How to grow Germs and Bacteria at Home? | Kid's Science Experiment Teaching About Hygiene
Step 1
Wash your hands with soap and water for 20 seconds.
Step 2
With an adult, wash the jar and spoon in hot soapy water and rinse well.
Step 3
Measure 4 cups 1 quart of milk into the saucepan.
Step 4
With an adult, heat the milk to 180°F 82°C while stirring occasionally and check the temperature with the thermometer.
Step 5
Remove the saucepan from heat and let the milk cool to 110°F 43°C using the thermometer to check.
Step 6
Pour about 1/2 cup of the cooled milk into the small bowl and stir in 2 tablespoons of the plain yogurt until smooth.
Step 7
Pour the starter mixture back into the cooled milk and stir gently for 30 seconds.
Step 8
Pour the milk mixture into the clean jar and close the lid loosely.
Step 9
Use the labeling tape to write today’s date and stick it on the jar.
Step 10
Wrap the jar in the towel and place it in a warm spot around 100–110°F 38–43°C to incubate for 4 to 8 hours.
Step 11
Put the jar in the refrigerator for at least 2 hours to let the yogurt thicken.
Step 12
Ask an adult to inspect the yogurt for any mold or off smells and then write your observations about texture color and smell in your notebook.
Step 13
Share your finished yogurt creation and observations on DIY.org.
Help!?
What can we substitute if we don't have a kitchen thermometer, a clean jar, or plain yogurt starter?
An adult can use a candy or instant-read meat thermometer to check 180°F and 110°F, any clean heatproof glass jar or mason jar in place of the labeled jar, and store-bought plain yogurt with live cultures as the starter.
My yogurt didn't thicken or smells off—what might have gone wrong and how can we fix it?
Check that the milk was heated to 180°F and then cooled to about 110°F before stirring in 2 tablespoons of plain yogurt, ensure the jar stayed wrapped in a warm 100–110°F spot for the full 4–8 hours, and discard any batch with visible mold or an off smell.
How can we adapt the steps for different age groups so it's safe and fun?
For younger kids have an adult do the hot steps while the child helps wash the jar, stir the starter into the 1/2 cup cooled milk, stick on the labeling tape, and draw observations in the notebook, whereas older kids can measure 4 cups of milk, monitor temperatures, and post the finished yogurt on DIY.org.
How can we extend or personalize the yogurt activity once it's set and refrigerated?
Try small experiments by labeling multiple jars with tape and different plain yogurt starters or milk types to compare texture, color, and smell after refrigeration, then flavor or decorate your finished yogurt before sharing observations on DIY.org.
Watch videos on how to grow a harmless bacteria culture by making yogurt
Growing Bacteria - Cool Science Experiment
Facts about food microbiology for kids
🥛 Yogurt is made when lactic acid bacteria turn milk sugars into lactic acid, which thickens the milk and gives yogurt its tangy flavor.
🦠 Common yogurt microbes include Lactobacillus and Streptococcus thermophilus — many are considered probiotic and friendly to digestion.
🔥 Heating milk before making yogurt helps change milk proteins so the final yogurt is thicker and creamier.
⏱️ Homemade yogurt usually takes about 4–12 hours to set — warmer temperatures make it set faster.
🧪 Just a small spoonful of live, store-bought yogurt can act as a starter culture to inoculate a whole batch of milk.
How do you grow a harmless bacteria culture by making yogurt with store-bought yogurt as a starter?
What materials do I need to make yogurt as a child-friendly bacteria culture activity?
What ages is this yogurt-making bacteria activity suitable for?
What safety tips should parents follow when doing a yogurt culture activity with children?